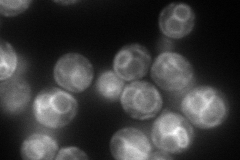
YPL019C
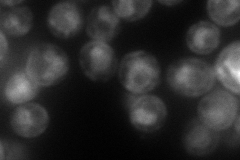
YPL019C
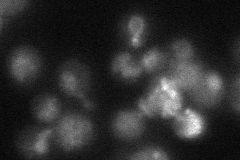
YPL019C
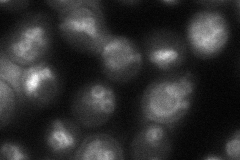
YPL019C
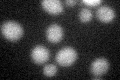
YPL019C

View description
Subunit of the vacuolar transporter chaperone (VTC) complex involved in membrane trafficking, vacuolar polyphosphate accumulation, microautophagy and non-autophagic vacuolar fusion
Localization:
Intensity:
Fold change:
Significance:
-
C’ GFP library in SD

below threshold15.72 -
N' NOP1pr-GFP in SD
vacuole membrane158.918 -
N' TEF2pr-mCherry in SD
cell periphery,vacuole membrane99.2107 -
N' NATIVEpr-GFP in SD
vacuole membrane21.8045 -
N' TEF2pr-VC and Cyto-VN in SD
vacuole membrane55.4834 -
C’ GFP library in SD+DTT
cytosol14.090.89No -
C’ GFP library in SD+H2O2

cytosol15.841No -
C’ GFP library in Starvation Media

cytosol18.421.17No -
C’ GFP library on the background of Pup2-DaMP

below threshold -
C’ GFP library on the background of CCT mutant

below threshold15.14830.963124No
